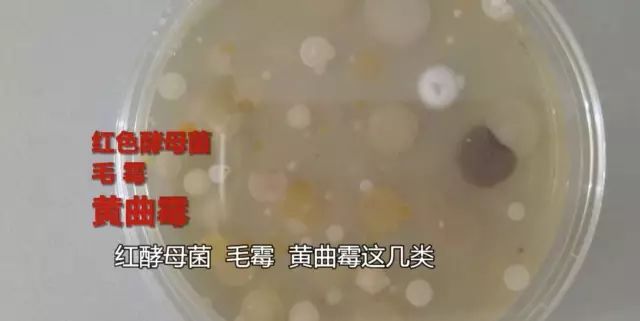

有人认为,蹲坑很脏,因为蹲坑冲水时产生的气旋很强烈,能把细菌带到人的鼻子、嘴巴高度,相当于“隔空吃屎”……这是真的吗?
通过实验,看一看吧~
荧光素钠,固态情况下是橘黄色,溶于水之后,只要拿紫外线一照,就会发出黄绿色的光芒。


这种水溶液可以牢牢吸附在物体表面,只要往马桶里加一点荧光素钠,就可以清晰地看到冲水时气旋的高度了。

在马桶和蹲坑正上方安置一块透明玻璃板,量了下距离,马桶和蹲坑到玻璃板的距离是一样的,看看气旋在这个高度有多强烈。


蹲坑上方的玻璃板可以看到大量水珠。

坐便器的情况也不是很好,同样有不少水滴,数量比蹲坑少一些。

提升玻璃板高度到40公分。

蹲坑果然还是有水滴溅上来。

坐便器上方的玻璃板则比较干净了。

玻璃板提高到60公分。

蹲坑冲水时依然能把水花带到这个高度,差不多是人站姿的上半身,如果你是蹲着回头按冲水的话……
医生说,这些被气旋带起来的水滴里,有不少细菌,因为细菌比水更轻,上升高度还可能更高。

蹲坑是直冲,所以溅起的水花细菌会更多,现在的坐便器多数采用虹吸式,细菌被带入下水道,从这个角度看,公厕的坐便器确实比蹲坑要干净些。

实验对公厕蹲坑冲水时带起的水花进行了细菌采样培养,发现其中含有不少致病菌,藤黄微球菌,枯草芽孢杆菌,大肠埃希菌,黑曲霉,烟曲霉,白色念珠菌,红色酵母菌等等。
可是公厕坐便器的马桶圈,始终是个很难克服的心理障碍,那么多人坐过的马桶圈,是不是真的很脏呢?

马桶圈有可能传染皮肤病,但是概率非常低,必须是一个有皮肤病的人刚坐过,然后一个臀部有伤口的人跟着坐下去,才有传染的可能,绝大部分情况下,坐便器还是安全的。
所以总的来说,从安全卫生的角度看,坐便器并不比蹲坑差,但是蹲坑也有优点,有研究表明,蹲着上厕所更轻松,不容易得痔疮和便秘。
资料:科普中国
编辑:吴百欣
杨浦区融媒体中心
